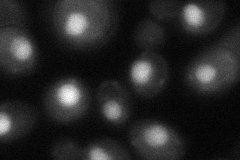

View description
Component of a complex containing Cef1p, putatively involved in pre-mRNA splicing; has similarity to S. pombe Cwf27p
Localization:
Intensity:
Fold change:
Significance:
-
C’ GFP library in SD

nucleus22.19 -
N' NOP1pr-GFP in SD

nucleus130.707 -
N' TEF2pr-mCherry in SD

nucleus108.662 -
N' NATIVEpr-GFP in SD

nucleus21.5816 -
N' TEF2pr-VC and Cyto-VN in SD
nucleus49.716 -
C’ GFP library in SD+DTT

nucleus20.010.9No -
C’ GFP library in SD+H2O2

nucleus22.050.99No -
C’ GFP library in Starvation Media

nucleus18.950.85No -
C’ GFP library on the background of Pup2-DaMP

nucleus -
C’ GFP library on the background of CCT mutant

nucleus24.95011.12405No
